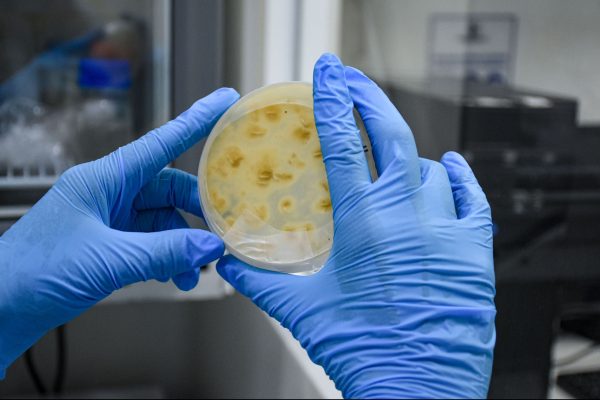

FABRIFARMA S.A, en adelante La Compañía, en cumplimiento a lo estipulado en la Ley 1581 de 2012 y a lo previsto en el Decreto 1377 de 2013, deja a su disposición el presente aviso de privacidad con el objeto de informar al titular de datos personales acerca de la existencia de las políticas y procedimientos de tratamiento de información adoptadas por La Compañía, la forma de acceder a estas y las características del tratamiento que se pretende dar a los datos.
 Fabricación de medicamentos y suplementos dietarios
Fabricación de medicamentos y suplementos dietarios
Liquidos (Jarabes y suspensiones)
Solídos (Polvos, Tabletas y Cápsulas)
semisolidos (Cremas).
 Análisis Fisicoquímicos
Análisis Fisicoquímicos
Analisis cualitativo y cuantitativo

 Análisis Microbiológicos
Análisis Microbiológicos
Analisis de control de calidad microbiologico para productos farmaceuticos no esteriles.
 Ensayos y/o Estudios
Ensayos y/o Estudios
Estudios de estabilidad (natural ó acelarada), Desarrollo y Validación de metodos analíticos y Apoyo en la elaboración y radicación de dossiers para obtención de registro sanitario INVIMA

Contactenos

Ubicación
Calle 30 No. 11g – 46

Email:
info@fabrifarma.com.co

Telefonos:
(602) 4898801 – 4898802